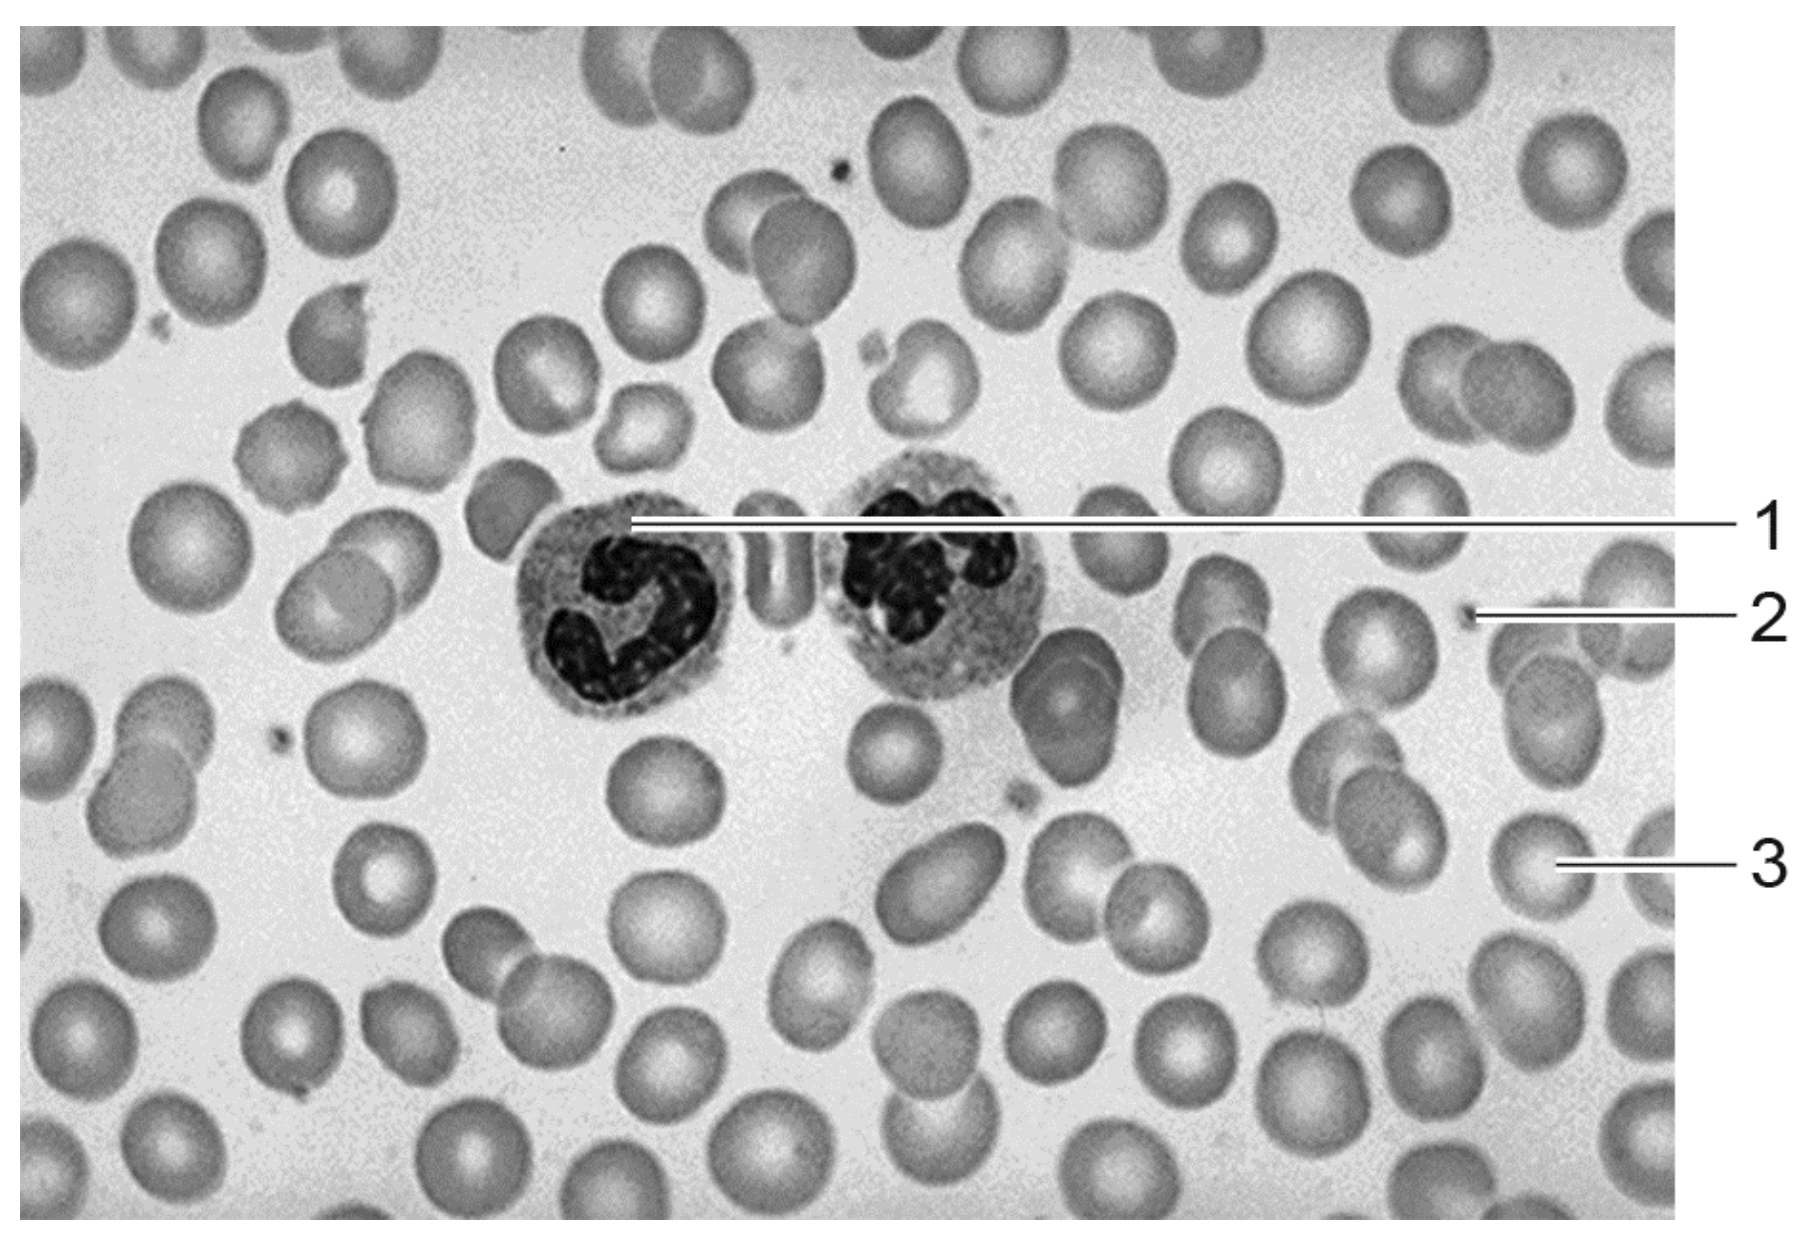
afbeelding 5

Je staat op een platform op een hoogte van 70 meter en laat je voorover de diepte in vallen (afbeelding 1). Hierbij gaat je lichaam over op de stress-stand.
Bij het overschakelen van het lichaam naar de stress-stand wordt het hormoon adrenaline afgegeven. |